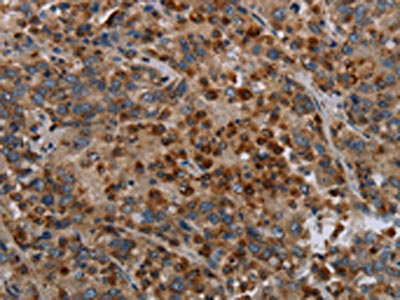

MAP3K11 Antibody
-
中文名稱:MAP3K11兔多克隆抗體
-
貨號:CSB-PA092285
-
規格:¥1100
-
圖片:
-
The image on the left is immunohistochemistry of paraffin-embedded Human colon cancer tissue using CSB-PA092285(MAP3K11 Antibody) at dilution 1/40, on the right is treated with synthetic peptide. (Original magnification: ×200)
-
The image on the left is immunohistochemistry of paraffin-embedded Human liver cancer tissue using CSB-PA092285(MAP3K11 Antibody) at dilution 1/40, on the right is treated with synthetic peptide. (Original magnification: ×200)
-
Gel: 6%SDS-PAGE, Lysate: 40 μg, Lane: LO2 cells, Primary antibody: CSB-PA092285(MAP3K11 Antibody) at dilution 1/400, Secondary antibody: Goat anti rabbit IgG at 1/8000 dilution, Exposure time: 40 seconds
-
-
其他:
產品詳情
-
Uniprot No.:
-
基因名:
-
別名:2610017K16Rik antibody; EC 2.7.11.25 antibody; M3K11_HUMAN antibody; Map3k11 antibody; MEKK11 antibody; MGC17114 antibody; Mitogen-activated protein kinase kinase kinase 11 antibody; Mixed lineage kinase 3 antibody; Mixed lineage protein kinase 3 antibody; Mlk-3 antibody; Mlk3 antibody; Protein tyrosine kinase PTK1 antibody; PTK1 antibody; RHOE antibody; SH3 domain containing proline rich kinase antibody; SPRK antibody; Src-homology 3 domain-containing proline-rich kinase antibody
-
宿主:Rabbit
-
反應種屬:Human,Mouse,Rat
-
免疫原:Synthetic peptide of Human MAP3K11
-
免疫原種屬:Homo sapiens (Human)
-
標記方式:Non-conjugated
-
抗體亞型:IgG
-
純化方式:Antigen affinity purification
-
濃度:It differs from different batches. Please contact us to confirm it.
-
保存緩沖液:-20°C, pH7.4 PBS, 0.05% NaN3, 40% Glycerol
-
產品提供形式:Liquid
-
應用范圍:ELISA,WB,IHC
-
推薦稀釋比:
Application Recommended Dilution ELISA 1:2000-1:5000 WB 1:500-1:2000 IHC 1:50-1:200 -
Protocols:
-
儲存條件:Upon receipt, store at -20°C or -80°C. Avoid repeated freeze.
-
貨期:Basically, we can dispatch the products out in 1-3 working days after receiving your orders. Delivery time maybe differs from different purchasing way or location, please kindly consult your local distributors for specific delivery time.
-
用途:For Research Use Only. Not for use in diagnostic or therapeutic procedures.
相關產品
靶點詳情
-
功能:Activates the JUN N-terminal pathway. Required for serum-stimulated cell proliferation and for mitogen and cytokine activation of MAPK14 (p38), MAPK3 (ERK) and MAPK8 (JNK1) through phosphorylation and activation of MAP2K4/MKK4 and MAP2K7/MKK7. Plays a role in mitogen-stimulated phosphorylation and activation of BRAF, but does not phosphorylate BRAF directly. Influences microtubule organization during the cell cycle.
-
基因功能參考文獻:
- These results suggest that in the early response to stressful stimuli, MLK4beta-MLK3 binding is important for regulating MLK3 activity and MAPK signalling, and after prolonged periods of stress exposure, MLK4beta and MLK3 proteins decline via CHIP-dependent degradation. PMID: 28757353
- In summary, this investigation identifies an EGFR-DOCK180-RAC1-MLK3-JNK signaling axis that drives glioblastoma cell migration and dissemination.IMPLICATIONS: On the basis of these findings, MLK3 emerges as a potential therapeutic target for the treatment of glioblastoma PMID: 28487380
- chronic hypoxia can reduce MLK3 expression in a posttranscriptional regulatory manner. PMID: 28555332
- Data indicate that BTG2, MAP3K11, RPS6KA1 and PRDM1 as putative targets of microRNA miR-125b. PMID: 27613090
- Increased expression of MAP3K11 is associated with esophageal cancer. PMID: 26717044
- MLK3 serves as a common upstream kinase of AMPK and JNK and functions as a direct upstream kinase for AMPK independent of LKB1 PMID: 25874865
- MLK3 represents a newly recognized integral component of HER2 biology in HER2+ breast tumors. PMID: 26152725
- MLK3 is a critical factor controlling the activity of kinase networks that control the cellular responses to different concentrations of reactive oxygen species. PMID: 24894995
- Signaling pathways associated with the Pro252His mutation in MLK3 are located in the kinase domain which is an important domain for the regulation of downstream signaling pathways. PMID: 24628919
- CHIP modulates MLK3 protein levels in response to Geldanamycin and stress stimuli, and CHIP-dependent regulation of MLK3 is required for suppression of SKOV3 ovarian cancer cell invasion. PMID: 24912674
- Data indicate URMC-099 as an orally bioavailable, potent mixed lineage kinase 3 MLK3 inhibitor. PMID: 24044867
- NS5A targets MLK3 with multiple downstream consequences for both apoptosis and K(+) homeostasis. PMID: 23857585
- Lysine 63-linked ubiquitination modulates mixed lineage kinase-3 interaction with JIP1 scaffold protein in cytokine-induced pancreatic beta cell death PMID: 23172226
- High MAP3K11 expression is associated with prostate cancer. PMID: 22761715
- Findings suggest that the MLK3-JNK-paxillin signaling axis may represent a potential prognostic marker in breast cancer metastasis. PMID: 22700880
- Data suggest that MEKK2 and MLK3 represent untargeted kinases in tumor biology for potential therapeutic development. PMID: 22139075
- The findings establish MLK3 as an important regulator of MMP expression and invasion in ovarian cancer cells. PMID: 22652451
- These findings collectively suggest that the MLK3-Pin1 signaling cascade plays a critical role in regulating the cell cycle, centrosome numbers, and oncogenesis. PMID: 22566623
- Data show that HBx can induce HepG2 cell apoptosis via a novel active MLK3-MKK7-JNKs signaling module to upregulate FasL protein expression. PMID: 22509080
- co-expression of MLK3 and beta-catenin resulted in significant G(2)/M arrest. PMID: 21880738
- These results establish merlin as a potent inhibitor of mixed lineage kinase 3, extracellular signal-regulated kinase, and c-jun N-terminal kinase activation in cancer. PMID: 20890305
- MLK3 is critical for breast cancer cell migration and promotes cell transformation. PMID: 20514022
- Studies indicate that the MLK3/JNK1 axis mediates G17-induced gastric cancer cell migration, which can be targeted for designing novel therapeutic strategies for treating gastric malignancies. PMID: 20150185
- Novel proteolytic processing of MLK3 may negatively control MLK3 signalling to JNK. PMID: 20158498
- MLK3 mutations is associated with the mismatch repair deficiency in gastrointestinal cancer. PMID: 19955118
- Estradiol inhibits the proapoptotic function of MLK3 as a mechanism to limit cytotoxic drug-induced death of ER(+) breast cancer cells. PMID: 20145118
- MLK3 functions to limit IKK activity, and depleting MLK3 helps protect cells from etoposide-induced cell death through activation of IKK-dependent signaling. PMID: 19782705
- MLK3 may be a negative regulator of the growth-promoting and transforming properties of Rac1 PMID: 11713255
- Twelve in vivo MLK3 phosphorylation sites have been identified. PMID: 11969422
- negative regulation by protein kinase B leads to cell survival PMID: 12458207
- ceramide and TNF-alpha are agonists PMID: 12504027
- MLK3 is phosphorylated by Akt2, which results in the disassembly of the JNK complex bound to POSH and down-regulation of the JNK signaling pathway PMID: 14504284
- MLK3 signaling requires Hsp90/p50cdc37 PMID: 15001580
- These observations support a role for mixed lineage kinases, including MLK3, in the TGF-beta1-induced cell death mechanism. PMID: 15069087
- MLK3 is required for mitogen activation of B-Raf, ERK and cell proliferation. PMID: 15258589
- The MLK3 might be a unique target to selectively inhibit transformed cell proliferation by disrupting mitotic spindle formation resulting in mitotic arrest. PMID: 15923109
- Cdc42 induces activation loop phosphorylation and membrane targeting of mixed lineage kinase 3 PMID: 16253996
- Merlin and MLK3 can interact in situ and merlin can disrupt the interactions between B-Raf and Raf-1 or those between MLK3 and either B-Raf or Raf-1. PMID: 16537381
- JNK-mediated feedback phosphorylation of MLK3 regulates its activation and deactivation states by cycling between Triton-soluble and Triton-insoluble forms PMID: 16687404
- a direct link between GSK-3beta and MLK3 activation in a neuronal cell death pathway and identify MLK3 as a direct downstream target of GSK-3beta. PMID: 17711861
- p38 MAPK inhibitors SB202190 and SB203580 activated JNK via MLK-3/MKK7 pathway. PMID: 18222647
- findings demonstrate a scaffolding role for MLK3 in controlling the extent of Rho activation that modulates cell migration PMID: 18851832
- K48-linked ubiquitination directs Mixed lineage kinase 3 for proteosomal degradation while K63-linked ubiquitination is important for Mixed lineage kinase 3 kinase activity. PMID: 19586614
顯示更多
收起更多
-
亞細胞定位:Cytoplasm, cytoskeleton, microtubule organizing center, centrosome. Note=Location is cell cycle dependent.
-
蛋白家族:Protein kinase superfamily, STE Ser/Thr protein kinase family, MAP kinase kinase kinase subfamily
-
組織特異性:Expressed in a wide variety of normal and neoplastic tissues including fetal lung, liver, heart and kidney, and adult lung, liver, heart, kidney, placenta, skeletal muscle, pancreas and brain.
-
數據庫鏈接:
Most popular with customers
-
YWHAB Recombinant Monoclonal Antibody
Applications: ELISA, WB, IHC, IF, FC
Species Reactivity: Human, Mouse, Rat
-
Phospho-YAP1 (S127) Recombinant Monoclonal Antibody
Applications: ELISA, WB, IHC
Species Reactivity: Human
-
-
-
-
-
-